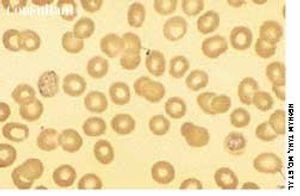

A 24-year-old woman was concerned about a protruding epigastrium mass that had grown since it was first noted 4 months earlier. She had no abdominal pain, nausea, or vomiting.

A 24-year-old woman was concerned about a protruding epigastrium mass that had grown since it was first noted 4 months earlier. She had no abdominal pain, nausea, or vomiting.

A 28-year-old woman reported that she was in good health before experiencing generalized weakness; exhaustion; and pain in her legs, shoulders, and back for the past 3 months. She also complained of shortness of breath with minimal activity, irregular menstrual periods, and occasional episodes of nose and gum bleeding.

Back pain and weakness of both legs had bothered this 60-year-old woman for 1 week. Left breast cancer, stage 2, had been diagnosed 2 years before, and subsequently she underwent a lumpectomy followed by chemotherapy and radiation therapy.

A 70-year-old woman with a history of ischemic heart disease was hospitalized because of generalized weakness, fatigue, and retrosternal chest pain on mild exertion. Her skin was pallid. Chest and heart evaluations were normal, and mild hepatosplenomegaly was discerned.

A 55-year-old woman with no significant medical history reported that diffuse erythematous, patchy, purpuric skin lesions over most of her body had been present for the past year. Applications of an over-the-counter corticosteroid cream helped control the pruritus but did not clear the skin lesions.

A 20-year-old woman, who had been confused and delirious for 2 days, was brought to the emergency department (ED). She had no significant past medical history and was taking no medication but had recently returned from a trip to Southeast Asia. In the ED, the patient had several convulsions and rapidly became comatose. She was unresponsive; her temperature was 37.9°C (100.3°F), and her blood pressure measured 80/50 mm Hg. The neurologic examination showed no signs of meningeal irritation. Cranial nerve examination was normal and showed mild, bilateral, symmetric increase in deep tendon reflexes. All other physical examination findings were normal.

Headache and vomiting suddenly developed in a 41-year-old woman who was 16 weeks pregnant. The next day, she suffered an episode of tonic-clonic seizures associated with a 15-minute loss of consciousness.

September 14th 2005

September 14th 2005

September 14th 2005

September 14th 2005

September 14th 2005
September 14th 2005